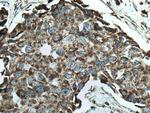
SFXN1 Antibody in Immunohistochemistry (Paraffin) (IHC (P))

Search
Proteintech
SFXN1 Polyclonal Antibody
{{$productOrderCtrl.translations['antibody.pdp.commerceCard.promotion.promotions']}}
{{$productOrderCtrl.translations['antibody.pdp.commerceCard.promotion.viewpromo']}}
{{$productOrderCtrl.translations['antibody.pdp.commerceCard.promotion.promocode']}}: {{promo.promoCode}} {{promo.promoTitle}} {{promo.promoDescription}}. {{$productOrderCtrl.translations['antibody.pdp.commerceCard.promotion.learnmore']}}
产品信息
12296-1-AP
种属反应
已发表种属
宿主/亚型
分类
类型
抗原
偶联物
形式
浓度
规格
纯化类型
保存液
内含物
保存条件
运输条件
产品详细信息
Immunogen sequence: MILIGRMSA QVPMNMTITG CMMTFYRTTP AVLFWQWINQ SFNAVVNYTN RSGDAPLTVN ELGTAYVSAT TGAVATALGL NALTKHVSPL IGRFVPFAAV AAANCINIPL MRQRELKVGI PVTDENGNRL GESANAAKQA ITQVVVSRIL MAAPGMAIPP FIMNTLEKKA FLKRFPWMSA PIQVGLVGFC LVFATPLCCA LFPQKSSMSV TSLEAELQAK IQESHPELRR VYFNKGL (87-322 aa encoded by BC020517)
靶标信息
Ran (ras-related nuclear protein) is a small GTP binding protein belonging to the RAS superfamily that is essential for the translocation of RNA and proteins through the nuclear pore complex. The Ran protein is also involved in control of DNA synthesis and cell cycle progression. Nuclear localization of Ran requires the presence of regulator of chromosome condensation 1 (RCC1).
仅用于科研。不用于诊断过程。未经明确授权不得转售。
生物信息学
蛋白别名: flexed tail; flexed-tail; Sideroflexin-1; tricarboxylate carrier protein; unnamed protein product
基因别名: 2810002O05Rik; A930015P12Rik; f; SFXN1; SLC56A1; TCC
UniProt ID: (Human) Q9H9B4, (Mouse) Q99JR1
Entrez Gene ID: (Human) 94081, (Mouse) 14057